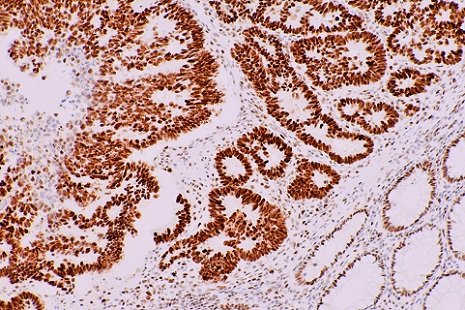

Clinical automated tissue stainer (IHC autostainer)

Automated slide stainer for research — pathology & cytology

Automated slide stainer for research (additional model option)

Primary antibodies for IHC

IHC detection/reagent kits

In situ hybridization (ISH) kits